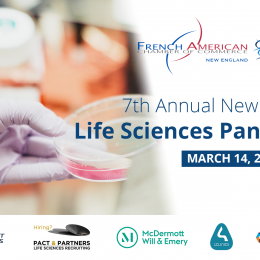

Thursday, Mar 14, 2019
Life Sciences Panorama
REGISTRATION IS CLOSED. An International Perspective on the BioPharma Industry from LifeScience and Business Leaders Given Boston's reputable role in scientific research and innovation, as well as its presence as a global biopharma hub, this annual event has become recognized by the life sciences community as an annual catalyst for information exchange among globally minded…...